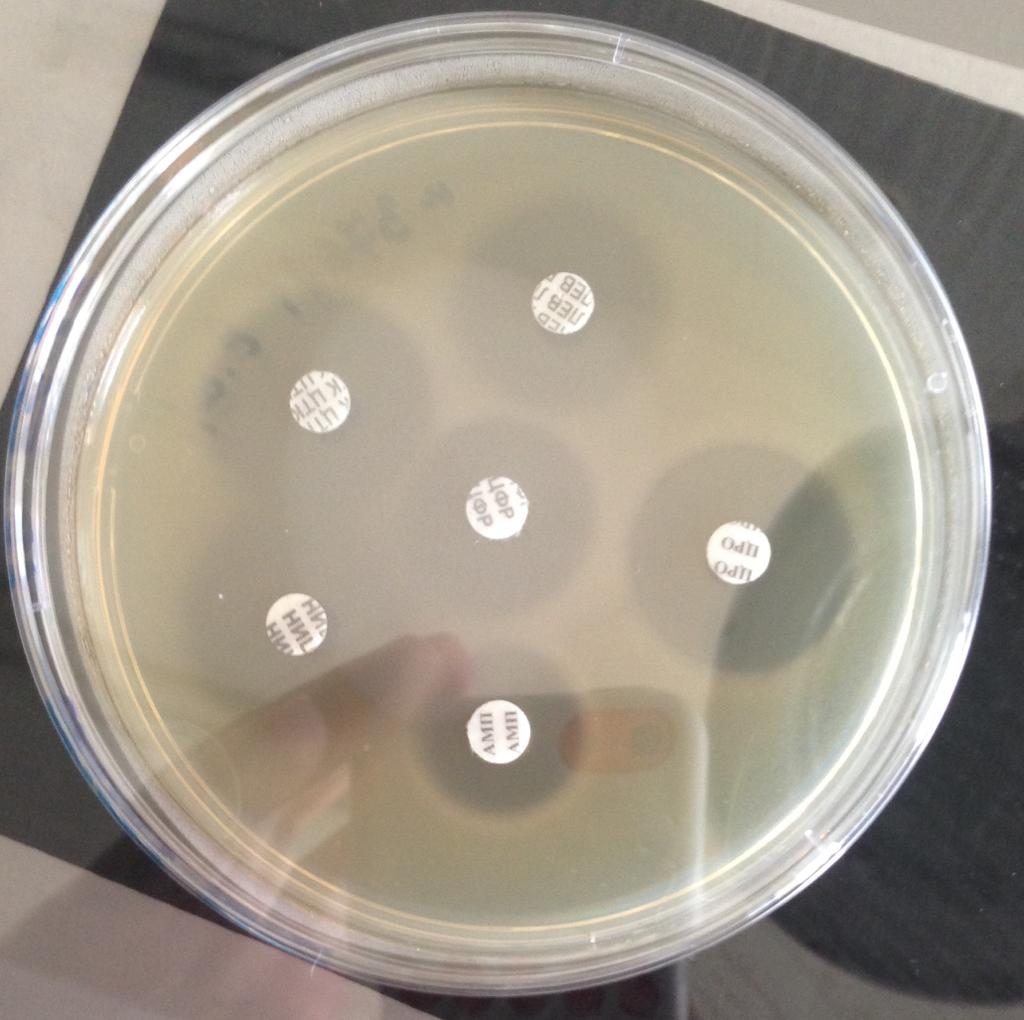

Амикацин Для Собак

⚡ 👉🏻👉🏻👉🏻 ВСЯ ИНФОРМАЦИЯ ДОСТУПНА ЗДЕСЬ, КЛИКАЙ 👈🏻👈🏻👈🏻
Амикацин для Собак, Кошек и др . Животных | Инструкция по . . .
Амикацин (Amikacinum)- описание вещества, инструкция . . .
Бордетеллёз у собак: симптомы и лечение бордетеллы . . .
Антибиотики для собак - уколы широкого спектра и . . .
Антибиотики для собак: уколы широкого спектра действия
Дозировка современных антибиотиков для собак и кошек
Антибиотики для собак широкого спектра действия: в . . .
Антибиотики для собак при простуде, цистите, гнойных ранах
Лекарства от чумки для собак: названия средств в таблетках . . .
Дозировки лекарств для собак, кошек, хорьков и прочих . . .
L Тироксин 50 Мкг
Авамис Взрослым
Купить Дешево Акатинол Мемантин 20 Мг
Правильная и своевременная очистка глаз и ушей от экссудата повысит эффективность местного лечения амикацином у собак и кошек . Амикацин и другие аминогликозиды обычно используются в офтальмологических препаратах для лечения язв роговицы .
Способ применения и дозы . В/м, в/в (струйно, в течение 2 мин, или капельно, со скоростью 60 капель в минуту) . Взрослым и детям: по 5 мг/кг каждые 8 ч или по 7,5 мг/кг каждые 12 ч; максимальная доза — 15 мг/кг/сут, курсовая доза не более 15 г .
Дозировка для собак (мг/кг) Дозировка для кошек (мг/кг) «Амикацин» 15-20 г 1 раз в сутки: 15-20 г 1 раз в сутки «Амоксициллин» 12,5-25 г каждые 12 часов: 12,5 г каждые 12 часов «Азитромицин» 3,3 г в сутки
гентамицин - по 1 таблекте в сутки, курс в 5 дней; кабактан - не назначают беременным сукам; фурагин - дают в виде таблеток, содержащих 0,05 грамм действующего вещества, доза для собак - ½ таблетки, трижды в день, курс - 1 неделя; уросульфин - по ½ таблетки (0,5 действующего . . .
Собаками назначают медикамент для лечения респираторных инфекций, устранения инфекций на коже и мягких тканях, а также для устранения недугов выделительной системы и ЖКТ .
Опасен для человека . Использовать в перчатках! Кошки: 12,5-20 мг/кг: 12 ч . Клиндамицин: п/о: Собаки: 5,5-33 мг/кг: 12 ч . Кошки: 11-33 мг/кг: 24 ч . Дифлоксацин: п/о: Собаки: 5-10 мг/кг: 24 ч . Энрофлоксацин: п/к, в/м: Собаки: 5-20 мг/кг: 24 ч .
Антибактериальные препараты незаменимы при лечении тяжелых заболеваний, таких как пневмония, менингит, отит, ангина, эндометрит, мастит и др . Не оказывают действие на здоровые органы и ткани . Недостатки применения проявляются в резистентности к ним бактерий при частом . . .
Антибиотики для собак имеют такое же большое значение, как и для людей . Узнать, какие антибиотики давать для лечения собаки можете в этой статье .
для взрослых собак - 0,2 см3/кг; для щенков - 0,3 см3/кг . Суточная дозировка: для взрослых собак - 0,6-0,9 см3/кг; для щенков - 0,9-1,2 см3/кг . Форвет: В вену или в мышцу; двукратная инъекция через 1-2 суток .
См выше + действует на нематод и личинок дирофилярий (Dirofilaria immitis) . Собаки: минимальная доза 2,5 мг/кг по афоксоланеру + 0,5 мг/кг по мильбемицину 1 раз в месяц . Выпускается в таблетках на собак весом 2-3,5 кг, 3,6-7,5 кг, 7,6-15 кг, 15,1-30 кг, 30,1-60 кг . Инъекционный раствор 10 мг/мл, таблетки по 10 . . .
Купить Форстео в Липецке
Купить Глицирризиновая кислота в Магнитогорске
Купить Монтлезир в Усолье-Сибирском
Купить Закваска в Дрезне
Купить Тыквеол в Выборге
Купить Дэтриферол в Солнечногорске
Купить Хондроитин в Мамадыше
Купить Витамины для больных диабетом метро Зябликово
Купить Ребагит в Домодедове
Купить Ирузид в Макушино
Купить Натива метро Менделеевская
Купить Прегинор в Кызыле
Купить Лоринден в Семикаракорске
Купить Софрадекс в Строителе
Купить Синагис в Павлово
Купить Лазин в Артёме
Купить Торендо в Ельце
Купить Топамакс в Буинске
Купить Нейромексол в Канске
Купить Флуцинар метро Цветной бульвар
Купить Нукс Вомика-Гомаккорд в Ростове
Купить Даунорубицин-Лэнс в Дивногорске
Купить Нованефрон в Десногорске
Купить Солкосерил в Кумертау
Купить Заноцин метро Павелецкая
Купить Добутамин в Ялуторовске
Купить Ротима метро Тверская
Купить Витабакт в Ладушкине
Купить Гета-сорб в Соль-Илецке
Купить Аримидекс в Новокубанске
Купить Холосас в Сердобске
Купить Метформин-тева в Москве
Купить Эслидин в Кувшиново
Купить Сольвенций в Энгельсе
Купить Нимулид в Тюмени
Купить Супероптик в Хотьково
Оксилик Аптека
Купить Флюанксол в Белоусове
Купить Тивикай в Слободском
Купить Будостер метро Тульская
Купить Апровель в Туринске
Купить Меларена в Беломорске
Купить Статиглин в Волжске
Купить Глиатилин в Усинске
Купить Ледис формула/Lady's formula в Сорочинске
Купить Кселевия метро Семеновская
Купить Виумксидин в Лесосибирске
Купить Арнигель метро Достоевская
Купить Микодерил метро Кузьминки
Купить Галвус в Жиздре
Купить Ремилакс метро Войковская
Купить Новостат в Чебоксарах
Купить Нормазе в Конаково
Купить Урифлорин в Люберцах
Купить Ревлимид в Феодосии
Купить Нутрифлекс в Джанкое
Купить Найсулид в Егорьевске
Купить Перлинганит в Козельске
Купить Юниэнзим в Истре
Купить Пефлоксацин в Каргополе
Купить Нурофаст в Сунже
Купить Проноран в Алексине
Купить Трихопол в Георгиевске
Купить Пуролаза в Сибае
Купить Лавакол в Уфе
Купить Фотил в Кургане
Диара (Лоперамид) Аптека
Купить Риностоп в Якутске
Купить Дип Рилиф метро Пятницкое шоссе
Купить Элидел в Цивильске
Купить Лемтрада в Амурске
Купить Телмиста в Верхнем Туре
Купить Артра в Лесозаводске
Купить Луцентис в Кингисеппе
Купить Синэстрол в Дзержинском
Купить Экко плюс в Новосиле
Купить Йодантипирин в Архангельске
Купить Корвалол в Ликино-Дулёво
Купить Клензит в Спасск-Рязанском
Купить Фленокс нео метро Тимирязевская
Купить Эдас в Красном Холме
Купить Нолтрексин в Белой Калитве
Купить Реаферон в Невьянске
Купить Фленокс нео в Липках
Купить Кларисенс в Сарове
Купить Ксалкори метро Волоколамская
Купить Тантум Роза в Бугуруслане
Купить Гельминдазол метро Рижская
Купить Цитозар в Апрелевке
Купить Туджео в Новомичуринске
Купить Викс в Новотроицке
Купить Дорипенем в Рыбном
Купить Фозиноприл в Цивильске
Купить Бевацизумаб в Козьмодемьянске
Купить Ланцид в Ермолине
Купить Дисоль в Судже
Купить Почечный чай (ортосифон) метро Крестьянская застава
Купить Велледиен в Марксе
Купить Тержинан метро Шипиловская
Купить Кораксан в Иванове
Амикацин Для Собак